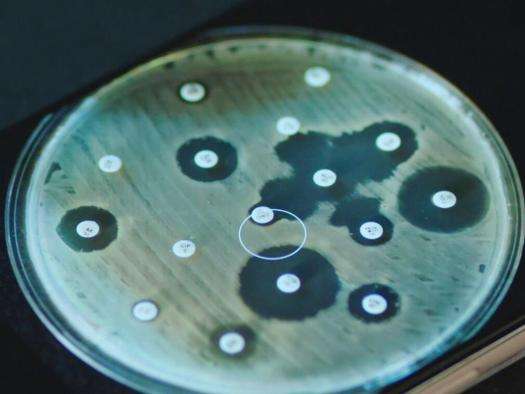
A person holds a phone with the Antibiogo application open and displays a close-up of an antibiogram.

World leaders must act now to respond to genocide in Gaza
News Sep 17, 2025
Get the latest news, stories, videos, and more from our medical humanitarian projects around the world.
Speaking out about the emergencies our staff and patients witness is part of who we are. Explore our history and principles.
Story | Dec 10, 2024
The town of Koro has become a shelter for thousands fleeing regional violence, but urgent assistance is needed for host communities overwhelmed by high needs.
Read more
Story | Nov 22, 2024
Discover key facts about malaria, the parasitic disease impacting millions.
Read more
Story | Sep 11, 2024
The rainy season in Magaria health district is marked by a surge in malaria and malnutrition cases each year.
Read more
Story | Jul 22, 2024
From wars to natural disasters, disease outbreaks, and long-neglected crises, MSF teams responded to a multitude of emergencies in 2023.
Read more
News | Mar 14, 2024
EU policies are denying safety and protection to refugees and migrants, while promoting systematic brutality.
Read more
Research | Nov 15, 2023
Resistance to antibiotics has become a global health crisis, complicating the treatment of bacterial infections and endangering lives around the world.
Read more
News | Sep 18, 2023
Low country vaccination rates and global shortage of diphtheria treatment is exacerbating the outbreak in Nigeria and regionally.
Read more
Story | Jul 12, 2023
Measles is a highly contagious disease that can easily spiral out of control without routine vaccinations.
Read more
News | Mar 16, 2023
Deported from Algeria, migrants are abandoned, left without protection or support.
Read more
Story | Dec 27, 2022
A year of MSF's medical activity around the world
Read more

Your unrestricted gifts enable us to provide lifesaving medical humanitarian care on the ground and speak out about what we see.